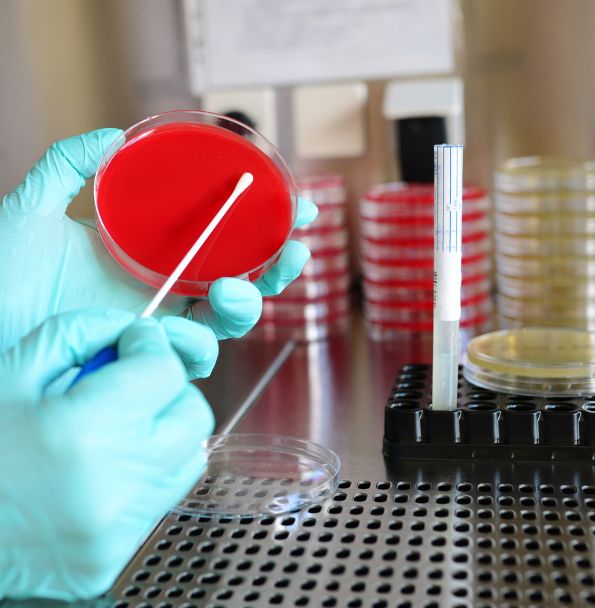
Gestión de Desechos Patológicos

Horarios
| Lun - Vie: | 9:00 am - 5:00 pm |
| Sabado: | Cerrado |
| Domingo: | Cerrado |
En Mediclean brindamos soluciones completas para la gestión de desechos patológicos, incluyendo retiro especializado, tratamiento certificado y eliminación responsable, cumpliendo estrictamente con el Decreto 1076 de 2015 y demás normativas ambientales vigentes.
Protocolos de bioseguridad para recolección de tejidos, fluidos y órganos en centros médicos y funerarios.
Procesos de incineración y esterilización autorizados por las autoridades ambientales competentes.
Sistema integral que garantiza el manejo adecuado desde la fuente hasta la disposición final.
Documentación completa con manifiestos, certificados y trazabilidad según requerimientos legales.











